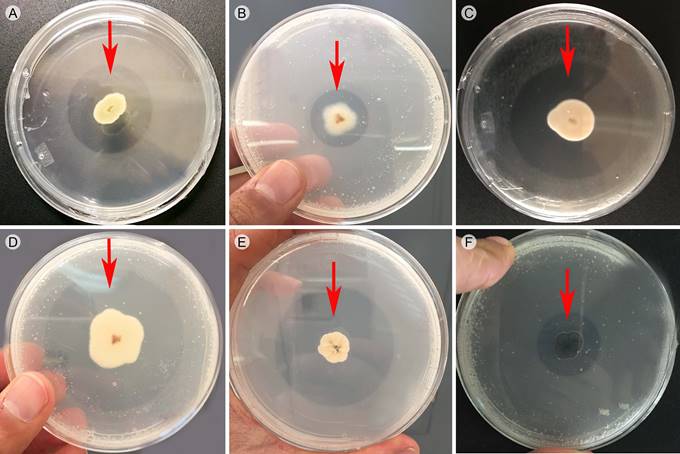

Artículos de investigación
Aislamiento y selección de hongos de suelo solubilizadores de fósforo nativos del estado de Coahuila, México
Isolation and selection of solubilizing phosphate soil fungi native to Coahuila state, Mexico
Aislamiento y selección de hongos de suelo solubilizadores de fósforo nativos del estado de Coahuila, México
Acta botánica mexicana, núm. 126, e1390, 2019
Instituto de Ecología A.C., Centro Regional del Bajío
Recepción: 14 Mayo 2018
Recibido del documento revisado: 26 Junio 2018
Aprobación: 22 Octubre 2018
Financiamiento
Fuente: Consejo Nacional de Ciencia y Tecnología
Nº de contrato: 610453
Descripción del financiamiento: Este estudio fue apoyado por el Consejo Nacional de Ciencia y Tecnología, mediante la beca para Maestría en Ciencias Biológicas (430083) a SIH.
Resumen:
Antecedentes y Objetivos: La deficiencia de fósforo en los cultivos agrícolas generalmente es atendida mediante la aplicación de fertilizantes. Sin embargo, estas prácticas resultan costosas y causan deterioro al medio ambiente. El uso de bio-productos como los hongos solubilizadores de fósforo constituyen una alternativa promisoria. El objetivo de este trabajo fue aislar y seleccionar hongos del suelo fosfato solubilizadores nativos de Coahuila, México, con potencial para ser utilizados como biofertilizantes.
Métodos: El aislamiento de los hongos se llevó a cabo mediante la técnica de filtración de partículas de suelo. La selección de las cepas se realizó en el medio de cultivo de Sundara con fosfato tricálcico; la capacidad fosfato solubilizadora se detectó visualmente mediante la presencia de halos hialinos en el medio de cultivo. La evaluación cualitativa se determinó mediante el índice de eficiencia de solubilización. En la evaluación cuantitativa, los cultivos se incubaron en medio líquido por 25 días y cada cinco se midió el P soluble, pH y biomasa fúngica.
Resultados clave: Se obtuvo un total de 271 aislamientos de hongos; de éstos 52.76% proyectaron resultados positivos a la prueba cualitativa de solubilización de fósforo. En cuanto a la eficiencia de solubilización, ésta fluctuó entre 2.06-6.85 unidades. Las cepas Sp. Mz54, Aspergillus sp. 4C19, Penicillium sp. Mu73, Penicillium sp. Mu77 y Penicillium sp. A56 presentaron los mayores índices de eficiencia de solubilización (t<0.005). En la medición cuantitativa, la cepa Penicillium sp. Mu73 solubilizó la mayor cantidad de fósforo (83.26 mg l-1) (t<0.005). De acuerdo con los análisis de regresión, el fósforo aumentó a medida que el pH decreció (r2=0.81).
Conclusiones: La cepa Penicillium sp. Mu73 tiene un alto potencial para ser utilizada como biofertilizante ya que promueve un alto contenido de fósforo soluble en condiciones in vitro.
Palabras clave: biofertilizantes+ fosfato tricálcico+ hongos filamentosos.
Abstract:
Background and Aims: Phosphorus deficiency in crops is generally remediated through the application of fertilizers. However, this practice is costly and deteriorates the environment. The use of biofertilizers such as phosphate-solubilizing fungi is a promising alternative. The objective of the present study was to isolate and select native phosphate-solubilizing soil fungi from Coahuila state, Mexico, with potential to be used as biofertilizers.
Methods: Fungal strains were isolated using the soil-particle washing technique. The selection of phosphate-solubilizing strains was performed in a Sundara medium with tricalcium phosphate, and phosphate-solubilizing capacity was visually detected based on the presence of hyaline halos. The qualitative evaluation was carried out by calculating the solubilization index. In the quantitative evaluation, the cultures were incubated for 25 days in liquid medium, and soluble P, pH, and fungal biomass were measured every five days.
Key results: A total of 271 strains of fungi were isolated. Of these isolates, 52.76% tested positive for phosphate solubilization in the qualitative evaluation. With regard to solubilization efficiency, the values ranged from 2.06-6.85. The strains Sp. Mz54, Aspergillus sp. 4C19, Penicillium sp. Mu73, Penicillium sp. Mu77, and Penicillium sp. A56 presented the highest solubilization efficiency indices (t<0.005). In the quantitative evaluation, the strain Penicillium sp. Mu73 solubilized the highest quantity of phosphorus (83.26 mg l-1) (t<0.005). According to the regression analyses, the phosphorus concentration increased as the pH decreased (r2=0.81).
Conclusions: The strain Penicillium sp. Mu73 has high potential for use as a biofertilizer because it solubilizes a high amount of phosphorus under in vitro conditions.
Key words: biofertilizers, filamentous fungi, tricalcium phosphate.
Introducción
En México, 60% de su territorio está constituido por ecosistemas áridos y semiáridos (Montaño et al., 2016). En los climas áridos, los suelos se caracterizan por presentar altos contenidos de carbonatos, pH alcalino, textura arcillosa, poca profundidad y baja disponibilidad de fósforo (Narro, 1985). La mayor parte del fósforo inorgánico se absorbe en la superficie del suelo o se precipita como fosfatos de hierro y aluminio en suelos ácidos y como fosfatos de calcio y magnesio en suelos alcalinos y calcáreos (Bolan, 1991). La disponibilidad de fósforo en los suelos en algunas regiones del estado de Coahuila es baja debido a que el carbonato de calcio produce inmovilización temporal o permanente del ion fosfato (Zamudio González et al., 2011).
La deficiencia de fósforo generalmente es atendida mediante la aplicación de fertilizantes químicos que, al ser aplicados en dosis superiores a las requeridas por los cultivos, conducen a riesgos de contaminación ambiental por su lixiviación hacia aguas subterráneas. Además, conlleva a la degradación de la calidad de los suelos por exceso de salinidad y a un incremento infructuoso en los costos de producción (Cárdenas-Navarro et al., 2004).
Una alternativa ecológicamente aceptable para reducir los insumos externos y mejorar la cantidad y calidad de los recursos internos del suelo es el uso de microorganismos debidamente seleccionados. En el suelo, existen interacciones sinérgicas entre los microorganismos que favorecen el crecimiento y desarrollo de las plantas (Fernández y Rodríguez, 2015). Entre estos microorganismos destacan los hongos solubilizadores de fósforo (HSF), los cuales juegan un rol fundamental en el ciclaje de fósforo en los suelos, ya que tienen la habilidad de transformar el fosfato orgánico e inorgánico al romper los enlaces que forma el fósforo con los iones metálicos de hierro, calcio y aluminio y así transformarlo en soluble (Restrepo-Franco et al., 2015). Los hongos solubilizadores de fósforo son parte de un gran grupo conocido como microorganismos promotores del crecimiento vegetal; gracias a la actividad de estos hongos, las plantas pueden aprovechar grandes reservas de fósforo insoluble que se encuentran fijadas a los minerales del suelo (Beltrán-Pineda, 2014).
Este trabajo se planteó con el objetivo de aislar y seleccionar cepas nativas de hongos del suelo del estado de Coahuila, con capacidad fosfato solubilizadora con potencial para ser utilizados como biofertilizantes.
Materiales y Métodos
Localización de los sitios de muestreo
Se eligieron cuatro sitios para la toma de muestras de suelo en el estado de Coahuila: sitio 1 (25º13'16''N, 100º23'44''O y 2870 m s.n.m) se encuentra en el municipio Arteaga; sitio 2 (27º59'N, 101º42'41''O y 510 m s.n.m.) municipio Múzquiz; sitio 3 (26º55'22''N, 102º7'22''O y 720 m s.n.m.), municipio Cuatro Ciénegas y sitio 4 (26º25'34''N, 101º19'5''O y 940 m s.n.m.), municipio Castaños (INEGI, 2014) (Fig. 1).

Los sitios de estudio representan los principales sistemas de cultivo de hortalizas en la región (SAGARPA, 2015).
Colecta de muestras de suelo
En cada sitio se seleccionaron tres puntos de muestreo separados por una distancia de 100 m. En cada punto se tomó una muestra de suelo de 250 g a una profundidad de 0-20 cm. Posteriormente, en el laboratorio las tres muestras de cada punto y de cada sitio se mezclaron para obtener una muestra mixta. El suelo se secó a temperatura ambiente y se almacenó a 5 ºC hasta su procesamiento para el aislamiento de los hongos.
De las muestras mixtas de cada uno de los sitios, se tomaron 100 g de suelo y se enviaron al laboratorio de análisis de suelos, plantas y agua del Instituto de Ecología, A.C. (INECOL) para realizar los análisis fisicoquímicos que a continuación se detallan. El pH se midió utilizando un potenciómetro (Mckean, 1993), el fósforo disponible se determinó siguiendo la técnica propuesta por Bray 1 (Bray y Kurtz, 1945), la conductividad eléctrica fue evaluada con un conductímetro, la retención de fósforo se calculó siguiendo la técnica propuesta por Blakemore (1981), la materia orgánica y carbono orgánico se cuantificaron con el método Walkley-Black modificado (Walkley y Black, 1934), el carbono total se cuantificó por el método de combustión seca (Nelson y Sommers, 1996), el nitrógeno total se analizó con un micro-Kjeldahl (Bremner, 1965), la relación carbono/nitrógeno por la técnica analizador carbono/nitrógeno, la textura se determinó mediante pipeta con destrucción de materia orgánica y dispersión con hexametafosfato de sodio. Con los porcentajes de limo, arena y arcilla se determinó la textura correspondiente en el triángulo de las texturas (Borja Martínez et al., 2015). Los análisis de suelo se apegaron a la norma NOM-021-RECNAT-2000 (SEMARNAT, 2002).
Aislamiento y selección de los hongos solubilizadores de fósforo
El aislamiento de los hongos del suelo se realizó con la técnica de filtración de partículas (Bills et al., 2004), que consiste en lavar 1 g de suelo en una serie de microtamices (1 mm, 500 µm, 250 µm y 150 µm) con agua purificada. Se tomaron las partículas de suelo atrapadas en el tamiz de 150 µm y se colocaron en tubos con agua destilada. Finalmente se tomaron 300 µl de la muestra de suelo y se colocaron en el medio de cultivo rosa de bengala con dicloran y cloranfenicol (Oxoid Limited, Basingstoke, Inglaterra). Las placas se incubaron por 15 días a 25 °C. Una vez crecidas, las colonias se transfirieron a tubos con el medio de cultivo papa dextrosa agar (BIOXON, Estado de México, México).
Una vez aisladas, se realizaron preparaciones en ácido láctico (10%) y se observaron bajo el microscopio compuesto (Nikon Eclipse 80i con interfase Nomarski, Tokio, Japón). Las cepas se identificaron a nivel de género con base en las características morfológicas de sus colonias y por la observación de sus características microscópicas (conidios, conidióforos, arreglo de conidios), siguiendo las obras de Gilman (1963), Barron (1968) y Domsch et al. (1980).
Para la selección de las cepas con capacidad fosfato solubilizadora, se empleó un medio de cultivo sólido revelador con 0.5 g l-1 de Ca3(PO4)2 (Sundara Rao y Sinha, 1963). En las placas de Petri de 90 × 15 mm, se realizaron las inoculaciones de cada una de las cepas aisladas y se dejaron en incubación a 25 ºC durante tres días. La capacidad de solubilización de fósforo se detectó mediante la presencia de un halo hialino alrededor de la colonia (Sundara Rao y Sinha, 1963).
Evaluación cualitativa de la eficiencia de solubilización de los hongos
Una vez seleccionadas las cepas solubilizadoras de fósforo, se procedió a medir el índice de eficiencia relativa de solubilización (ERS). Se inocularon las cepas (tres repeticiones) en placas de Petri con medio de cultivo descrito en el párrafo anterior y diariamente durante 10 días se midieron el diámetro del halo formado y el de la colonia.
El índice de eficiencia relativa de solubilización se calculó mediante la fórmula: ERS=diámetro de la colonia + diámetro del halo de solubilización/diámetro de la colonia (Vitorino et al., 2012). Los diámetros se midieron desde el centro de la colonia. Para categorizar el nivel de solubilización de las cepas, se realizó una selección de acuerdo con su índice de ERS. Así se establecieron tres escalas: escala baja I=ERS de 2-2.9 cm; escala media II=ERS de 3-4.9 cm y escala alta III=ERS de 5-6.9 cm (escala empleada por Silva Filho y Vidor, 2000).
Evaluación cuantitativa de la eficiencia de solubilización de los hongos
Las cepas seleccionadas por su mayor índice de eficiencia relativa de solubilización se inocularon en matraces de 250 ml, con 100 ml de medio de cultivo líquido de Sundara Rao y Sinha (1963), adicionado con 0.5 g l-1 de Ca3(PO4)2 como fuente de fósforo insoluble. Los matraces fueron inoculados con cinco discos de 5 mm de diámetro de micelio de los hongos solubilizadores seleccionados con 15 días de crecimiento. Se utilizaron tres réplicas para cada cepa incluyendo un testigo (sin hongo).
Los cultivos se incubaron en la oscuridad a 25 ºC durante 25 días sin movimiento. A partir del día cinco y cada cinco días se realizaron los muestreos. En cada muestreo, se registraron el pH y la biomasa fúngica. Para obtener los extractos fúngicos, se filtraron las muestras en papel filtro Whatman® del número 42 y se procedió a medir el contenido de fósforo. El fósforo soluble se valoró por el método del ácido ascórbico (Clesceri et al., 1992), las absorbancias se midieron en un espectrofotómetro (Thermo Scientific GENESYS 10S UV Vis, Madison, EUA) a 880 nm. Los datos se compararon con una curva estándar de fósforo y se expresaron en mg l-1.
Análisis de los datos
En la evaluación cualitativa para detectar diferencias entre los valores de los índices de solubilización se realizaron Anovas de una vía. Para la evaluación cuantitativa, se efectuaron Anovas de una vía con medidas repetidas para conocer las diferencias del fósforo solubilizado entre las cepas inoculadas a través del tiempo de incubación. Cuando las diferencias fueron significativas se realizó la prueba de comparación de medias de Tukey (p≤0.05).
Para conocer la relación entre el contenido de fósforo soluble con el pH y la biomasa fúngica, se llevó a cabo un análisis de regresión simple. Asimismo, se realizó un análisis de regresión lineal simple entre el número de cepas aisladas, el número de cepas positivas a la solubilización, con los valores de los análisis fisicoquímicos de los sitios de estudio. Todos los análisis estadísticos se realizaron en el programa Statistica v. 8.0 (StatSoft Inc., 2007).
Resultados
Aislamiento y selección de cepas de hongos solubilizadores de fósforo
A partir de las muestras de suelos de los cuatro sitios se obtuvo un total de 271 aislamientos de hongos del suelo.
La identificación a nivel de género de algunos de los hongos se realizó considerando las características de las colonias en PDA y observaciones de preparaciones semipermanentes en ácido láctico bajo el microscopio compuesto. La mayoría de las cepas se identificaron como Aspergillus P. Micheli, Penicillium Link, Trichoderma Pers. y Fusarium Link.
La mayor cantidad de cepas provinieron de los sitios 2 (Múzquiz (84)) y 4 (Castaños (83)), seguidos del 1 (Arteaga (63)) y 3 (Cuatro Ciénegas (41)). La evaluación de la actividad solubilizadora reveló una respuesta positiva con la formación de halos hialinos alrededor de las colonias (Fig. 2) en 143 de los 271 aislamientos evaluados.
Este dato representa 52.76% de los aislamientos totales. El sitio Castaños presentó 42 hongos positivos, seguido de Arteaga (39), Múzquiz (38) y, por último, Cuatro Ciénegas (24).
En el análisis de regresión lineal se detectó una relación positiva significativa entre el número de cepas positivas a la solubilización de fósforo con la relación carbono/nitrógeno (R2=0.9972, p=0.001) (Fig. 3A).

A pesar de no ser significativa se observó una tendencia entre el número de cepas aisladas y la relación carbono/nitrógeno (R2=0.8191, p=0.07) (Fig. 3B). Es decir, en los sitios con mayor relación carbono/nitrógeno (Arteaga, Múzquiz y Castaños) se recuperó una mayor cantidad de cepas de hongos del suelo y se detectó el mayor número de cepas fosfato solubilizadoras
En Arteaga, Múzquiz y Castaños, la relación carbono/nitrógeno fue de 22-24%, mientras que en Cuatro Ciénegas fue de 13 (Cuadro 1).

Evaluación cualitativa de eficiencia de solubilización de los hongos
En los resultados de la evaluación cualitativa, los índices de solubilización mostraron una variación significativa entre las cepas evaluadas (F=16.25, p=0.00005). Los valores de los índices de solubilización estuvieron en un rango de 2.06-6.85. De acuerdo con las escalas establecidas; nueve cepas se ubicaron en la escala III (alta), 112 cepas en la escala II (media) y 22 cepas en la escala I (baja) de solubilización (Cuadro 2).

Las cepas colocadas en la mayor escala de solubilización (III) fueron los aislados Aspergillus sp. Mu42, 4C19, Penicillium sp. A56, Mu54, Mu73, Mu77 y Sp. Mu28, Mu82, Mz54. Entre las cepas de mayor escala de solubilización se revelaron diferencias significativas entre los valores del índice de eficiencia de solubilización (p<0.0005). Los valores de eficiencia de solubilización de las cepas Sp. Mz54, Aspergillus sp. 4C19, Penicillium sp. Mu73, Mu77 y A56 fueron significativamente mayores que en Sp. Mu82, Mu28, Penicillium sp. Mu54 y Aspergillus sp. Mu42 (t<0.005).
Evaluación cuantitativa de eficiencia de solubilización de los hongos
Con respecto a la eficiencia de solubilización en el medio líquido; los valores de fósforo soluble mostraron una variación significativa entre las nueve cepas evaluadas (F=60.82, p=0.00005) y a través del tiempo de incubación (F=72.39, p=0.00005).
El día de máxima solubilización en la mayoría de las cepas fue el día 15 de incubación. En este punto se detectó también la máxima actividad solubilizadora, con un rango de 65.84-83.26 mg l-1. La cepa Penicillium sp. Mu73 exhibió la mayor concentración de fósforo soluble (83.26 mg l-1) (t<0.00005). En el tratamiento control, el rango de solubilización fue de 2.8-12.6 mg l-1. La concentración de fósforo soluble en todas las cepas evaluadas aumentó a medida que el pH del medio decrecía (Figs. 4A-I); sin embargo, en el tratamiento control el pH se mantuvo sin descender (Fig. 4J).

A través de un análisis de regresión lineal simple, se corroboró que el contenido de fósforo soluble se relaciona de manera negativa y fuertemente significativa con el pH del medio de cultivo (p<0.005) (Fig. 5).

La relación entre el fósforo soluble y la biomasa fúngica no fue significativa (p>0.005).
Discusión
Aislamiento y selección de cepas de hongos solubilizadores de fósforo
Son pocos los estudios encaminados al conocimiento de la micoflora del suelo en general y del estado de Coahuila, en particular. Entre los pocos trabajos publicados figura el de Samaniego et al. (1988), quienes aislaron 115 especies de hongos de suelo de dos huertas de nogales infestados con Phymatotrichum omnivorum Duggar, con el objetivo de seleccionar hongos antagónicos en la supervivencia o patogenicidad de este hongo fitopatógeno. Samaniego y Chew-Madinaveitia (2007), en un estudio de biodiversidad para conocer la estructura de géneros de hongos del suelo en tres campos de cultivo agrícola (dos de nogal y uno de alfalfa), aislaron 23 géneros en los cultivos de nogal y 12 en el cultivo de alfalfa.
En el presente estudio, se obtuvo un total de 271 cepas de hongos de los sitios Múzquiz (84), Castaños (83), Arteaga (63) y Cuatro Ciénegas (41). Cabe señalar que estos sitios no habían sido muestreados para hongos del suelo anteriormente, por lo que representa una importante contribución para el estado de Coahuila. A pesar de que este estudio no tiene un enfoque taxonómico, se ubicaron algunas cepas a nivel de género. En los estudios mencionados anteriormente, así como en el presente trabajo, sobresalen Penicillium, Aspergillus y Fusarium. Estos géneros son representantes de zonas áridas (Flanagan, 1981).
A la fecha no existen estudios que hagan referencia al potencial de los hongos solubilizadores de fosfato, nativos de suelos del estado de Coahuila. En México, específicamente para el estado de Veracruz, existen algunos estudios sobre hongos solubilizadores de fósforo. Hernández-Leal et al. (2011) evaluaron in vitro la solubilización de compuestos fosfatados por Paecilomyces lilacinus (Thom) Samson en medios de cultivo sólidos y líquidos. Posada et al. (2012), mediante pruebas cualitativas, aislaron cepas de hongos del suelo de cafetales y seleccionaron cepas solubilizadores de fosfato de calcio (40) y de fosfato de hierro (48). Lima-Rivera et al. (2016) evaluaron la efectividad de dos cepas de hongos solubilizadoras de fosfato de calcio (Geomyces pannorum Singler y Carmichy, Metarhizium carneum (Duché & R. Heim) Kepler, S.A. Rehner & Humber) en la reducción de la población del nematodo Globodera rostochiensis (Wollenweber) Skarbilovich. Recientemente Perea et al. (2018) evaluaron el efecto de la interacción de hongos micorrícicos y solubilizadores de fósforo (Aspergillus niger Tiegh. y Penicillium brevicompactum Dierckx), en el desarrollo de plantas de café (Coffea arabica L. variedad Garnica). Estos microorganismos están fuertemente involucrados en la transformación de fósforo a través de la solubilización, mineralización e inmovilización (Begonia et al., 2004). Gracias a la efectividad de este tipo de microorganismos se ha logrado la disminución de la aplicación de fertilizantes químicos en algunos cultivos importantes como los de papa (Ñústez y Acevedo, 2005), maíz (Patil et al., 2012) y chícharo (Ramírez Gil et al., 2013). La reducción en el uso de fertilizantes químicos demanda la creación de estrategias alternativas que mantengan una producción vegetal competitiva y sin deterioro del medio ambiente. En este contexto, el uso de hongos del suelo que solubilizan fosfato insoluble posee gran potencial para ser utilizados como biofertilizantes, ya que constituyen medios ecológicamente plausibles para reducir los insumos externos y mejorar la calidad de los recursos internos.
Los análisis de regresión indican que tanto el número de cepas aisladas como el de respuestas positivas a la solubilización de fósforo se relacionan con el porcentaje de carbono/nitrógeno del suelo de los sitios muestreados. El mayor número de cepas aisladas y de cepas con capacidad fosfato solubilizadora se recuperaron en Castaños (sitio 4), Arteaga (S1) y Múzquiz (S2); en éstos la relación carbono/nitrógeno fue mayor (22-24%). Es bien sabido que una adecuada disponibilidad de carbono favorece la actividad de los microorganismos heterótrofos y regula su capacidad de mineralizar el nitrógeno y el fósforo (Montaño et al., 2016).
Evaluación cualitativa de eficiencia de solubilización de los hongos
El empleo de las pruebas reveladoras, mediante la presencia o la formación de halos hialinos alrededor de la colonia en el medio sólido, es una determinación rápida y ampliamente utilizada por diversos autores (Vera et al., 2002; Moratto et al., 2005; Noppararat et al., 2007; Oliveira et al., 2009; Verma y Ekka, 2015; Elías et al., 2016; Hajjam y Cherkaoui, 2017). Esta prueba resultó de gran utilidad para detectar cualitativamente las cepas con capacidad solubilizadora.
En este estudio 52.76% de los hongos aislados resultaron positivos por su capacidad para solubilizar fósforo; la mayoría de las cepas que expresaron respuesta positiva pertenecen a los géneros Penicillium y Aspergillus. Éstos han sido relacionados como solubilizadores de fósforo en numerosas investigaciones (Kumar et al., 2014; Rathore et al., 2014; Yasser et al., 2014; Verma y Ekka, 2015).
Existen investigaciones que señalan que Aspergillus y Penicillium poseen una alta capacidad de solubilización (Asea et al., 1988; Cunnigham y Kuiack, 1992; Vassilev et al., 1996; Nunes-Silva et al., 2002; Pandey et al., 2008; Morales et al., 2011; Rathore et al., 2014; Gizaw et al., 2017). Se ha expresado que la capacidad solubilizadora del fósforo por parte de los géneros indicados está relacionada con la habilidad de producción de ácidos orgánicos ( Swaby y Sperber, 1958; Roche y De Barac, 1959), lo cual produce el descenso del pH (Sperber, 1958). La acidificación del medio, producto del metabolismo fúngico, es el principal mecanismo involucrado en el proceso de solubilización (Beltrán-Pineda, 2014): 1) como resultado de la excreción de protones a través de ATPasas de la membrana plasmática, 2) del intercambio de protones en la absorción de nutrientes, 3) por la producción de ácidos orgánicos que son el producto del metabolismo de péptidos, lípidos y carbohidratos, y finalmente 4) por la producción de dióxido de carbono durante la respiración fúngica (Relwani et al., 2008). En la acidificación, los ácidos orgánicos actúan como agentes quelantes o secuestradores del ion asociado (Al3+, Ca2+, Fe3+ y Mg2+) dejando disponible el fósforo en forma de ortofosfato (Picone y Zamuner, 2002).
A la fecha, la mayoría de los estudios sobre hongos solubilizadores in vitro se han desarrollado con diversas cepas de Aspergillus niger (Vassilev et al., 1996; Narsian y Patel., 2000; Singh et al., 2011Ashok et al., 2012; Zeroual et al., 2012). Numerosos trabajos (Mesa Garriga et al., 2005; Velásquez et al., 2010; Paredes-Mendoza y Espinosa-Victoria, 2010; Leal et al., 2011; Pérez et al., 2012) evidencian que A. niger produce una gran cantidad de ácidos orgánicos tales como ácido cítrico, láctico, málico, oxálico o tartárico (Paredes-Mendoza y Espinosa-Victoria, 2010; Pérez et al., 2012). En la actualidad, existen en el mercado dos biofertilizantes elaborados con especies del género Penicillium; el producto JumpStart® a base de Penicillium bilaiae Chalab. elaborado en Canadá, y Fosfosol® cuyo ingrediente principal es Penicillium janthinellum Biourge, fabricado en Colombia. De acuerdo con los análisis estadísticos, las mejores cepas considerando los valores de los índices de eficiencia de solubilización son: el aislamiento no identificado Sp. Mz54, Aspergillus sp. 4C19, Penicillium sp. Mu73, Penicillium sp. Mu77 y Penicillium sp. A56.
En este trabajo, la cepa Penicillium sp. A56 presentó el índice de solubilización más alto (ERS=6.85). Estos valores ERS pertenecen a diámetros de los halos de 3-8.2 cm. De Freitas et al. (1997) sugieren que las cepas que forman halos alrededor de sus colonias con diámetros superiores a 1.5 cm, se consideran buenos solubilizadores de fósforo. En la literatura se han registrado valores de índice de solubilización de fosfato de hasta 5.3 ERS para Trichosporon beigelii (Küchenm. & Rabenh.) Vuill. (Hajjam y Cherkaoui, 2017), de 3 ERS para Paecilomyces lilacinus (Hernández-Leal et al., 2011); 2.87 para Aspergillus sp. (Elías et al., 2016) y de 2.25 ERS para Penicillium purpureogenum Stoll (Verma y Ekka, 2015). En esta publicación, los valores de ERS para las nueve cepas dispuestas en la escala más alta de solubilización (escala III) fueron de 5.35-6.85.
Los estudios de Narsian y Patel (2000), Reddy et al. (2002), Barroso y Nahas (2002) y Mittal et al. (2008) indican que la eficiencia de disolución del fosfato tricálcico depende del tipo de fuente de fósforo utilizada, el tipo de microrganismo, así como de la calidad y cantidad de ácidos orgánicos secretados en el medio de cultivo.
Evaluación cuantitativa de eficiencia de solubilización de los hongos
Comparando los resultados de la cepa con mayor capacidad fosfato solubilizadora, Penicillium sp MU73, en el medio líquido, se observa que sus valores de fósforo solubilizado (83.26 mg/L día 15 de incubación) son mayores a los reportados para una cepa de Paecilomyces lilacinus (71.28 mg/L día 12) (Hernández-Leal et al., 2011) (día 15); para diferentes cepas de Penicillium (9-65 mg/L) (Morales et al., 2011), Penicillium aurantiogriseum Dierckx (77.70 mg/L) (día 7); P. claviforme Bainier (75.01 mg/L) y Aspergillus niger (80.22 mg/L) (Saxena et al., 2013) (día 12); Mucor sp. Micheli y Penicillium sp. (59.16 y 55.58 mg/L, respectivamente) (Rathore et al., 2014) (día 21); Penicillium sp. (20.7 mg/L) (Moreno Quevedo et al., 2015) (día 15); para Geomyces pannorum (71.40 mg/L) (Lima-Rivera et al., 2016) (día 15) y para cepas de Aspergillus spp. (37-50 mg/L), Fusarium sp. (30 mg/L), Trichoderma viride Pers., (37 mg/L) y Penicillium sp. 1 y Penicillium sp. 2 (54-27 mg/L) (Selvi et al., 2017) (día 15). Fueron similares a las obtenidas para Paecilomyces carneus (83.2 mg/L) (Lima-Rivera et al., 2016) (día 18). Sin embargo, la concentración de fósforo disuelto fue menor que la reportada para Aspergillus sp. (167.7 mg/L) (Rathore et al., 2014) (día 21); Aspergillus niger (93.5 mg/L) (Moreno Quevedo et al., 2015) (día 15). Cabe señalar que en todos estos trabajos se utilizó fosfato tricálcico (0.5 g/L) como fuente de fósforo inorgánico y el fósforo se midió por la técnica de ácido ascórbico (Clesceri et al., 1992). Es importante señalar que, además de la mayoría de las cepas evaluadas en este estudio, así como en las cepas de los estudios anteriormente señalados, en el día 15 de incubación ocurrió la mayor solubilización de fósforo.
La producción de fósforo soluble se relacionó con el descenso del pH en el medio líquido; los resultados sugieren la liberación de ácidos orgánicos de bajo peso molecular por parte de los hongos, cuyas propiedades quelantes favorecen la formación de complejos insolubles con metales, con la consecuente liberación del fosfato (Fernández et al., 2005); estos resultados experimentales concuerdan con estudios previos (Pandey et al., 2008, Saxena et al., 2013, Selvi et al., 2017). Whitelaw et al. (1997), Pradhan y Sukla (2006) y Varsha et al. (2010) mencionan que los microorganismos fosfato solubilizantes disuelven el fosfato insoluble, mediante la producción de ácidos inorgánicos u orgánicos, lo que resulta en la disminución de los valores de pH. En este estudio, el cultivo de Penicillium sp. Mu73 fue en el que se obtuvo la mayor concentración de fosfato soluble (83.26 mg/L) y también se detectó una significativa disminución de pH (2.5 a los 15 días de incubación).
De acuerdo con la evaluación cualitativa y cuantitativa, la cepa Penicillium sp. Mu73 tiene un alto potencial para ser utilizada como biofertilizante ya que promueve un alto contenido de fósforo soluble en condiciones in vitro. Es importante puntualizar que se requieren experimentos en vivero y condiciones de campo para evaluar el efecto de estos hongos como bioinoculantes sobre el rendimiento de los cultivos.
Contribución de autores
RMA y ARF idearon y diseñaron el estudio, aislaron las cepas de hongos del suelo, realizaron las pruebas cualitativas y cuantitativas de solubilización de fósforo, los análisis estadísticos e interpretaron los resultados y escribieron el manuscrito. RMV participó en la selección de los sitios de estudio y la colecta de las muestras de suelo. Todos los autores contribuyeron a la revisión y aprobación del manuscrito final.
Agradecimientos
Al Laboratorio de Micromicetos Saprobios del Instituto de Ecología, A.C., por las facilidades brindadas para la realización de este estudio. A Allison Marie Jermain por la traducción del resumen al inglés.
Literatura citada
Asea, P. E. A., R. M. N. Kucey y J. W. B. Stewart. 1988. Inorganic phosphate solubilization by two Penicillium species in solution culture and soil. Soil Biology and Biochemistry 20(4): 459-464. DOI: https://doi.org/10.1016/0038-0717(88)90058-2
Ashok, V. G., S. S. Sabina y G. D. Preeti. 2012. Isolation and identification of phosphate solubilizing fungi from rhizosphere (soil). International Journal of Science Innovation and Discoveries 2: 310-315.
Barron, G. L. 1968. The genera of Hyphomycetes from soil. The Williams and Wilkings Company. New York, USA. 364 pp.
Barroso, C. B. y E. Nahas. 2002. Solubilization of hardly soluble iron and aluminum phosphates by the fungus Aspergillus niger in the soil. First International Meeting on Microbial Phosphate Solubilization. Developments in Plant and Soil Sciences 102: 193-198. DOI: https://doi.org/10.1007/978-1-4020-5765-6_29
Begonia, M. T., G. B. Begonia, G. Miller, D. Gilliard y C. Young. 2004. Phosphatase activity and populations of microorganisms from cadmium and lead contaminated soils. Bulletin of Environmental Contamination and Toxicology 73(6): 1025-1032. DOI: https://doi.org/10.1007/s00128-004-0528-4
Beltrán-Pineda, M. E. 2014. La solubilización de fosfatos como estrategia microbiana para promover el crecimiento vegetal. Corpoica Ciencia y Tecnología Agropecuaria 15(1): 101-113. DOI: https://doi.org/10.21930/rcta.vol15_num1_art:401
Bills, G., M. Christensen, M. Powell y G. Thorn. 2004. Saprobic soil fungi. In: Mueller, G. M., G. F. Bills y M. S. Foster (eds.). Biodiversity of Fungi: Inventory and Monitoring Methods. Elsevier. Amsterdam, The Netherlands. Pp. 271-302.
Blakemore, L. C. 1981. Soil Bureau laboratory methods: A methods for chemical analysis of soils. New Zealand Soil Bureau Scientific Report 10: 8-1. DOI: https://dx.doi.org/10.7931/DL1-SBSR-10A
Bolan, N. S. 1991. A critical review on the role of mycorrhizal fungi in the uptake of phosphorus by plants. Plant and Soil 134(2): 189-207. DOI: https://doi.org/10.1007/bf00012037
Borja Martínez, K., J. Mercado Lázaro y E. M. Combatt Caballero. 2015. Dispersantes químicos y cuantificación de fracciones texturales por los métodos Bouyoucos y pipeta. Acta Agronómica 64(4): 308-314. DOI: https://doi.org/10.15446/acag.v64n4.45722
Bray, R. H. y L. T. Kurtz. 1945. Determination of total, organic and available forms of phosphorus in soil. Soil Science 59(1): 39-46. DOI: https://doi.org/10.1097/00010694-194501000-00006
Bremner, J. M. 1965. Inorganic forms of nitrogen. Agronomy 9: 1179-1237.
Cárdenas-Navarro, R., J. M. Sánchez-Yánez, R. Farías-Rodríguez y J. J. Peña-Cabriales. 2004. Los aportes de nitrógeno en la agricultura. Revista Chapingo Serie Horticultura 10(2): 173-178. DOI: https://doi.org/10.5154/r.rchsh.2002.07.039
Clesceri, L. S., A. E. Greenberg y R. R. Trussell. 1992. Métodos normalizados para el análisis de aguas potables y residuales. Ed. Díaz de Santos, S.A. Madrid, España. Pp. 4-187.
Cunningham, J. E. y C. Kuiack. 1992. Production of citric and oxalic acids and solubilization of calcium phosphate by Penicillium bilaii. Applied and Environmental Microbiology 58(5): 1451-1458.
De Freitas, J. R., M. R. Banerjee y J. J. Germida. 1997. Phosphate-solubilizing rhizobacteria enhance the growth and yield but not phosphorus uptake of canola (Brassica napus L.). Biology and Fertility of Soils 24(4): 358-364. DOI: https://doi.org/10.1007/s003740050258
Domsch, K. H., W. Gams y T. H. Anderson. 1980. Compendium of soil fungi. Volume 1. Academic Press. London, UK. 860 pp.
Elías, F., D. Woyessa y D. Muleta. 2016. Phosphate solubilization potential of rhizosphere fungi isolated from plants in Jimma Zone, Southwest Ethiopia. International Journal of Microbiology 2016: 1-11. DOI: https://dx.doi.org/10.1155/2016/5472601
Fernández, M. y H. Rodríguez. 2015. El papel de la solubilización del fósforo en los fertilizantes microbianos. ICIDCA: Sobre los Derivados de la Caña de Azúcar 39(3): 27-34.
Fernández, L. A., P. Zalba, M. A. Gómez y M. A. Sagardoy. 2005. Bacterias solubilizadoras de fosfato inorgánico aisladas de suelos de la región sojera. Ciencia del Suelo 23(1): 31-37.
Flanagan, P. W. 1981. Fungal taxa, physiological groups and biomass: a comparison between ecosystems. In: Wicklow, D. T. y G. C. Carroll (eds.). The fungal community. Marcell Dekker. New York, USA. Pp. 569-592.
Gilman, J. C. 1963. Manual de los hongos del suelo. CECSA. México, D.F., México. 572 pp.
Gizaw, B., Z. Tsegay, G. Tefera, E. Aynalem, M. Wassie y E. Abatneh. 2017. Phosphate solubilizing fungi isolated and characterized from Teff rhizosphere soil collected from North Showa zone, Ethiopia. African Journal of Microbiology Research 11(17): 687-696. DOI: https://doi.org/10.5897/AJMR2017.8525
Hajjam, Y. y S. Cherkaoui . 2017. The influence of phosphate solubilizing microorganisms on symbiotic nitrogen fixation: Perspectives for sustainable agriculture. Journal of Materials 8(3): 801-808.
Hernández-Leal, T., G. Carrión y G. Heredia. 2011. Solubilización in vitro de fosfatos por una cepa de Paecilomyces lilacinus (Thom) Samson. Agrociencia 45(8): 881-892.
Index Fungorum. 2018. Index Fungorum base de datos. http://www.indexfungorum.org/Names/Names.asp (consultado julio de 2018).
INEGI. 2014. Anuario estadístico y geográfico de Coahuila de Zaragoza. Cd. Mx., México. 501 pp.
Kumar, M. V., P. A. Kumar, K. K. Sanjay y S. B. Pratap. 2014. Molecular characterization of phosphate solubilizing fungi associated with rhizopheric soils of banana. Science Technology Journal 2(1): 57-66.
Leal, D., Y. Pico, J. Castro, J. Guerra y G. Castro. 2011. Producción de ácido cítrico a partir de suero lácteo entero e hidrolizado con Aspergillus niger, por vía fermentativa. Alimentos Hoy 19(19): 32-38.
Lima-Rivera, D. L., D. López-Lima, D. Desgarennes, A. S. Velázquez-Rodríguez y G. Carrión. 2016. Phosphate solubilization by fungi with nematicidal potential. Journal of Soil Science and Plant Nutrition 16(2): 507-524. DOI: https://dx.doi.org/10.4067/S0718-95162016005000042
Mckean, S. 1993. Manual de análisis de suelos y tejido vegetal: una guía teórica y práctica de metodologías. Centro Internacional de Agricultura Tropical CIAT. Cali, Colombia. Pp. 9-10.
Mesa Garriga, L., E. González Suárez, R. de la Cruz y Y. López. 2005. Avances en la producción de ácido cítrico a partir de miel final por Aspergillus niger. Revista Cubana de Química 17(1): 171-178.
Mittal, V., O. Singh, H. Nayyar, J. Kaur y R. Tewari. 2008. Stimulatory effect of phosphate-solubilizing fungal strains (Aspergillus awamori and Penicillium citrinum) on the yield of chickpea (Cicer arietinum L. cv. GPF2). Soil Biology and Biochemistry 40(3): 718-727. DOI: https://doi.org/10.1016/j.soilbio.2007.10.008
Montaño, N. M., F. Ayala, S. H. Bullock, O. Briones, F. García, O. R. García, S. Y. Maya, Y. Perroni, C. Siebe, Y. Tapia, T. E. Troyo y E. Yépez. 2016. Almacenes y flujos de carbono en ecosistemas áridos y semiáridos de México: Síntesis y perspectivas. Terra Latinoamericana 34: 39-59.
Morales, A., M. Alvear, E. Valenzuela, C. E. Castillo y F. Borie. 2011. Screening, evaluation and selection of phosphate-solubilising fungi as potential biofertiliser. Journal of Soil Science and Plant Nutrition 11(4): 89-103. DOI: https://doi.org/10.4067/S0718-95162011000400007
Moratto, C., L. J. Martínez, H. Valencia y J. Sánchez. 2005. Efecto del uso del suelo sobre hongos solubilizadores de fosfato y bacterias diazotróficas en el páramo de Guerrero (Cundinamarca). Agronomía Colombiana 23(2): 299-309.
Moreno Quevedo, A. P., N. W. Osorio Vega y O. A. González Murillo. 2015. In vitro dissolution of acidulated rock phosphate by phosphate solubilizing microorganisms. Acta Biológica Colombiana 20(2): 65-71. DOI: https://dx.doi.org/10.15446/abc.v20n2.42713
Narsian, V. y H. H. Patel . 2000. Aspergillus aculeatus as a rock phosphate solubilizer. Soil Biology and Biochemistry 32(4): 559-565. DOI: https://doi.org/10.1016/S0038-0717(99)00184-4
Narro, F. E. 1985. Mejoradores de suelos calcáreos y fertilización fosfatada en el cultivo de la papa. Agraria, Revista Científica UAAAN 1(1): 57-70.
Nelson, D. W y L. E. Sommers . 1996. Total carbon, organic carbon and organic matter. In: Sparks, D. L. (ed.). Methods of Soil Analysis. Part 3: chemical methods. Soil Science Society of America. Madison, USA. Pp. 961-1010.
Nopparat, C., M.Jatupornpipat y A.Rittiboon. 2007. Isolation of phosphate solubilizing fungi in soil from Kanchanaburi, Thailand. Journal of Science and Technology 7(2): 137-146.
Nunes-Silva, G., C. Narloch y R. Scharf. 2002. Solubilização de fosfatos naturais por microrganismos isolados de cultivos de Pinus e Eucalyptus de Santa Catarina. Pesquisa Agropecuária Brasileira 37(6): 847-854. DOI: https://dx.doi.org/10.1590/S0100-204X2002000600014
Ñústez, C. E. y J. C. Acevedo . 2005. Evaluación del uso de Penicillium janthinellum Biourge sobre la eficiencia de la fertilización fosfórica en el cultivo de la papa (Solanum tuberosum L. var. Diacol Capiro). Agronomía Colombiana 23(2): 290-298.
Oliveira, C. A., V. M. C. Alves, I. E. Marriel, E. A. Gomes, M. R. Scotti, N. P. Carneiro, C. T. Guimarães, R. E. Schaffert y N. M. H. Sá.2009. Phosphate solubilizing microorganisms isolated from rhizosphere of maize cultivated in an oxisol of the Brazilian Cerrado Biome. Soil Biology and Biochemistry 41(4): 1782-1787. DOI: https://doi.org/10.1016/j.soilbio.2008.01.012
Pandey, A., N. Das, B. Kumar, K. Rinu y P. Trivedi. 2008. Phosphate solubilization by Penicillium spp. isolated from soil samples of Indian Himalayan region. World Journal of Microbiology and Biotechnology 24(1): 97-102. DOI: https://doi.org/10.1007/s11274-007-9444-1
Paredes-Mendoza, M. y D. Espinosa-Victoria. 2010. Ácidos orgánicos producidos por rizobacterias que solubilizan fosfatos: una revisión crítica. Terra Latinoamericana 28(1): 61-70.
Patil, P. M., V. B. Kuligod, N. S. Hebsur, C. R. Patil y G. N. Kulkarni. 2012. Effect of phosphate solubilizing fungi and phosphorus levels on growth, yield and nutrient content in maize (Zea mays). Karnataka Journal of Agricultural Sciences 25(1): 58-62.
Perea Rojas, Y. C., R. M. Arias, R. Medel Ortiz, D. Trejo, G. Heredia y Y. Rodríguez Yon. 2018. Effects of native arbuscular mycorrhizal and phosphate-solubilizing fungi on coffee plants. Agroforestry Systems (2018)1-12. DOI: https://doi.org/10.1007/s10457-018-0190-1
Pérez, C. A., V. J. de la Ossa y V. D. Montes. 2012. Hongos solubilizadores de fosfatos en fincas ganaderas del departamento de Sucre. Revista Colombiana de Ciencia Animal 4(1): 35-45.
Picone, L. y E. Zamuner . 2002. Fósforo orgánico y fertilidad fosfórica. Informaciones Agronómicas del Cono Sur 16: 11-15.
Posada, R., M. Sánchez de Prager, E. Sieverding, K. Aguilar y G. Heredia. 2012. Relaciones entre los hongos filamentosos y solubilizadores de fosfatos con algunas variables edáficas y el manejo de cafetales. Revista de Biología Tropical 60(3): 1075-1096. DOI: https://doi.org/10.15517/rbt.v60i3.1759
Pradhan, N. y L. B. Sukla . 2006. Solubilization of inorganic phosphates by fungi isolated from agriculture soil. African Journal of Biotechnology 5(10): 850-854.
Ramírez Gil, J. G., L. Osorno Bedoya, N. W. Osorio Vega y J. G. Morales Osorio. 2013. Alternativas microbiológicas para mejorar el crecimiento del caupí. Revista Facultad Nacional de Agronomía Medellín 66(2): 7035-7044.
Rathore, P., N. Phanse y B. Patel. 2014. Screening for microorganisms possessing phosphate solubilizing potential. Indian Journal of Research 3(1): 172-174. DOI: https://doi.org/10.15373/22501991/JAN2014/53
Reddy, M. S., S. Kumar, K. Babita y M. S. Reddy. 2002. Biosolubilization of poorly soluble rock phosphates by Aspergillus tubingensis and Aspergillus niger. Bioresource Technology 84(2): 187-189. DOI: https://doi.org/10.1016/S0960-8524(02)00040-8
Relwani, L., P. Krishna y M. S. Reddy. 2008. Effect of carbon and nitrogen sources on phosphate solubilization by a wild-type strain and UV-induced mutants of Aspergillus tubingensis. Current Microbiology 57(5): 401-406. DOI: https://doi.org/10.1007/s00284-008-9212-y
Restrepo-Franco, G., S. Marulanda-Moreno, Y. de la Fe-Pérez, A. Díaz-de la Osa, V. Lucia-Baldani y A. Hernández-Rodríguez. 2015. Bacterias solubilizadoras de fosfato y sus potencialidades de uso en la promoción del crecimiento de cultivos de importancia económica. Revista CENIC Ciencias Biológicas 46(1): 63-76.
Roche, A. y De Barsac . 1959. Solubilization de phosphate naturelles par les germes du sol. Annales De I'Instut Pasteur 96: 781-789.
SAGARPA. 2015. Agenda técnica agrícola de Coahuila. Segunda edición. Secretaría de Agricultura, Ganadería, Desarrollo Rural, Pesca y Alimentación. México, D.F., México. Pp. 1- 127.
Samaniego, J. A. y Y. Chew-Madinaveitia . 2007. Diversidad de géneros de hongos del suelo en tres campos con diferente condición agrícola en La Laguna, México. Revista Mexicana de Biodiversidad 78(2): 383-390.
Samaniego, J. A., M. Ulloa y T. Herrera . 1988. Micobiota del suelo en huertas de nogal atacadas por Phymatotrichum omnivorum en Coahuila, México. Revista Mexicana de Micología 4: 43-57.
Saxena, J., P. Basu, V. Jaligam y S. Chandra . 2013. Phosphate solubilization by a few fungal strains belonging to the genera Aspergillus and Penicillium. African Journal of Microbiology Research 7(41): 4862-4869. DOI: https://doi.org/10.5897/AJMR2013.5991
Selvi, K. B., J. J. A. Paul, V. Vijaya y K. Saraswathi . 2017. Analyzing the efficacy of phosphate solubilizing microorganisms by enrichment culture techniques. Biochemistry and Molecular Biology Journal 3(1): 1-7. DOI: https://doi.org/10.21767/2471-8084.100029
SEMARNAT. 2002. Norma Oficial Mexicana NOM-021-RECNAT-2000, que establece las especificaciones de fertilidad, salinidad y clasificación de los suelos. Estudios, muestreo y análisis. Secretaria de Medio Ambiente y Recursos Naturales. Diario Oficial de la Federación. Segunda sección. 31 de diciembre 2002. Cd. Mx., México. Pp. 1-75.
Silva Filho, G. N. y C. Vidor . 2000. Solubilização de fosfatos por microrganismos na presença de fontes de carbono. Revista Brasileira de Ciência do Solo 24(2): 311-329. DOI: https://dx.doi.org/10.1590/S0100-06832000000200008
Singh, M. S., L. S. Yadav, S. K. Singh, P. Singh, P. N. Singh y R. Ravindra. 2011. Phosphate solubilizing ability of two Arctic Aspergillus niger strains. Polar Research 30(1): DOI: https://doi.org/10.3402/polar.v30i0.7283
Sperber, J. I. 1958. The incidence of apatite-solubilizing organisms in the rhizosphere and soil. Australian Journal of Agricultural Research 9(6): 778-781. DOI: https://doi.org/10.1071/AR9580778
StatSoft Inc. 2007. Statistica para Windows v. 8.0. Data analysis software system. Tulsa, USA.
Sundara Rao, W. y M. K. Sinha . 1963. Phosphate dissolving organisms in the soil and rizosphere. Indian Journal of Science 33: 272-278.
Swaby, R. J. y J. I. Sperber . 1958. Phosphate dissolving microorganisms in the rhizosphere of legumes. In: Hollworth, E. G. (ed.). Nutrition of the legumes. Academic Press. New York, USA. Pp. 289-294.
Varsha, M., M. Nidhi , y M. Anurag. 2010. Heavy metals in plants: phytoremediation: plants used to remediate heavy metal pollution. Agriculture and Biology Journal of North America 1(1): 40-46.
Vassilev, N., I. Franco, M. Vassileva y R. Azcon . 1996. Improved plant growth with rock phosphate solubilized by Aspergillus niger grown on sugar-beet waste. Bioresource Technology 55(3): 237-241. DOI: https://doi.org/10.1016/0960-8524(96)00008-9
Velásquez, J., F. D. Beltrán, L. Padilla y G. Giraldo. 2010. Obtención de ácido cítrico por fermentación con Aspergillus niger utilizando sustrato de plátano Dominico-Hartón (Musa AAB Simmonds) maduro. Tumbaga 1(5): 135-147.
Vera, D. F., H. Pérez y H. Valencia. 2002. Aislamiento de hongos solubilizadores de fosfatos de la rizosfera de arazá (Eugenia stipitata, Myrtaceae). Acta Biológica Colombiana 7(1): 33-40.
Verma, A. y A. Ekka . 2015. Isolation, screening and assessment of phosphate solubiling efficiency of some fungal isolates of Raipur, Chhattisgarh. Journal of Environmental Science Toxicology and Food Technology 1(1): 29-39.
Vitorino, L. C., F. G. Silva, M. A. Soares, E. L. Souchie, A. Costa y W. Lima. 2012. Solubilization of calcium and iron phosphate and in vitro production of Indoleacetic acid by Endophytic isolates of Hyptis marrubioides Epling (Lamiaceae). International Research Journal of Biotechnology 3(4): 47-54.
Walkley, A. e I. A. Black . 1934. An examination of the Degtjareff method for determining soil organic matter, and a proposed modification of the chromic acid titration method. Soil Science 37(1): 29-38.
Whitelaw, S., K. McKeown y J. Williams. 1997. Global health promotion models: enlightenment or entrapment? Health Education Research 12(4): 479-490. DOI: https://doi.org/10.1093/her/12.4.479
Yasser, M. M., A. S. M. Mousa, O. N. Massoud y S. H. Nasr. 2014. Solubilization of inorganic phosphate by phosphate solubilizing fungi isolated from Egyptian soils. Journal of Biology and Earth Sciences 4(1): 83-90.
Zamudio González, A., A. Vázquez, G. Alcántar González, J. D. Etchevers Barra y M. Tadeo Robledo. 2011. Movimiento vertical de fósforo en suelos arenosos con fertirriego y uso de mejoradores. Terra Latinoamericana 29(3): 249-258.
Zeroual, Y., R. Chadghan, A. Hakam y A. Kossir. 2012. Biosolubilization of mineral insoluble phosphates by immobilized fungi (Aspergillus niger) in fluidized bed bioreactor. Journal of Biotechnology and Biomaterials 6: 1-5. DOI: https://doi.org/10.4172/2155-952X.S6-004
Citar como:
Financiamiento
Notas de autor
5Autor para la correspondencia: ariasrm27@gmail.com